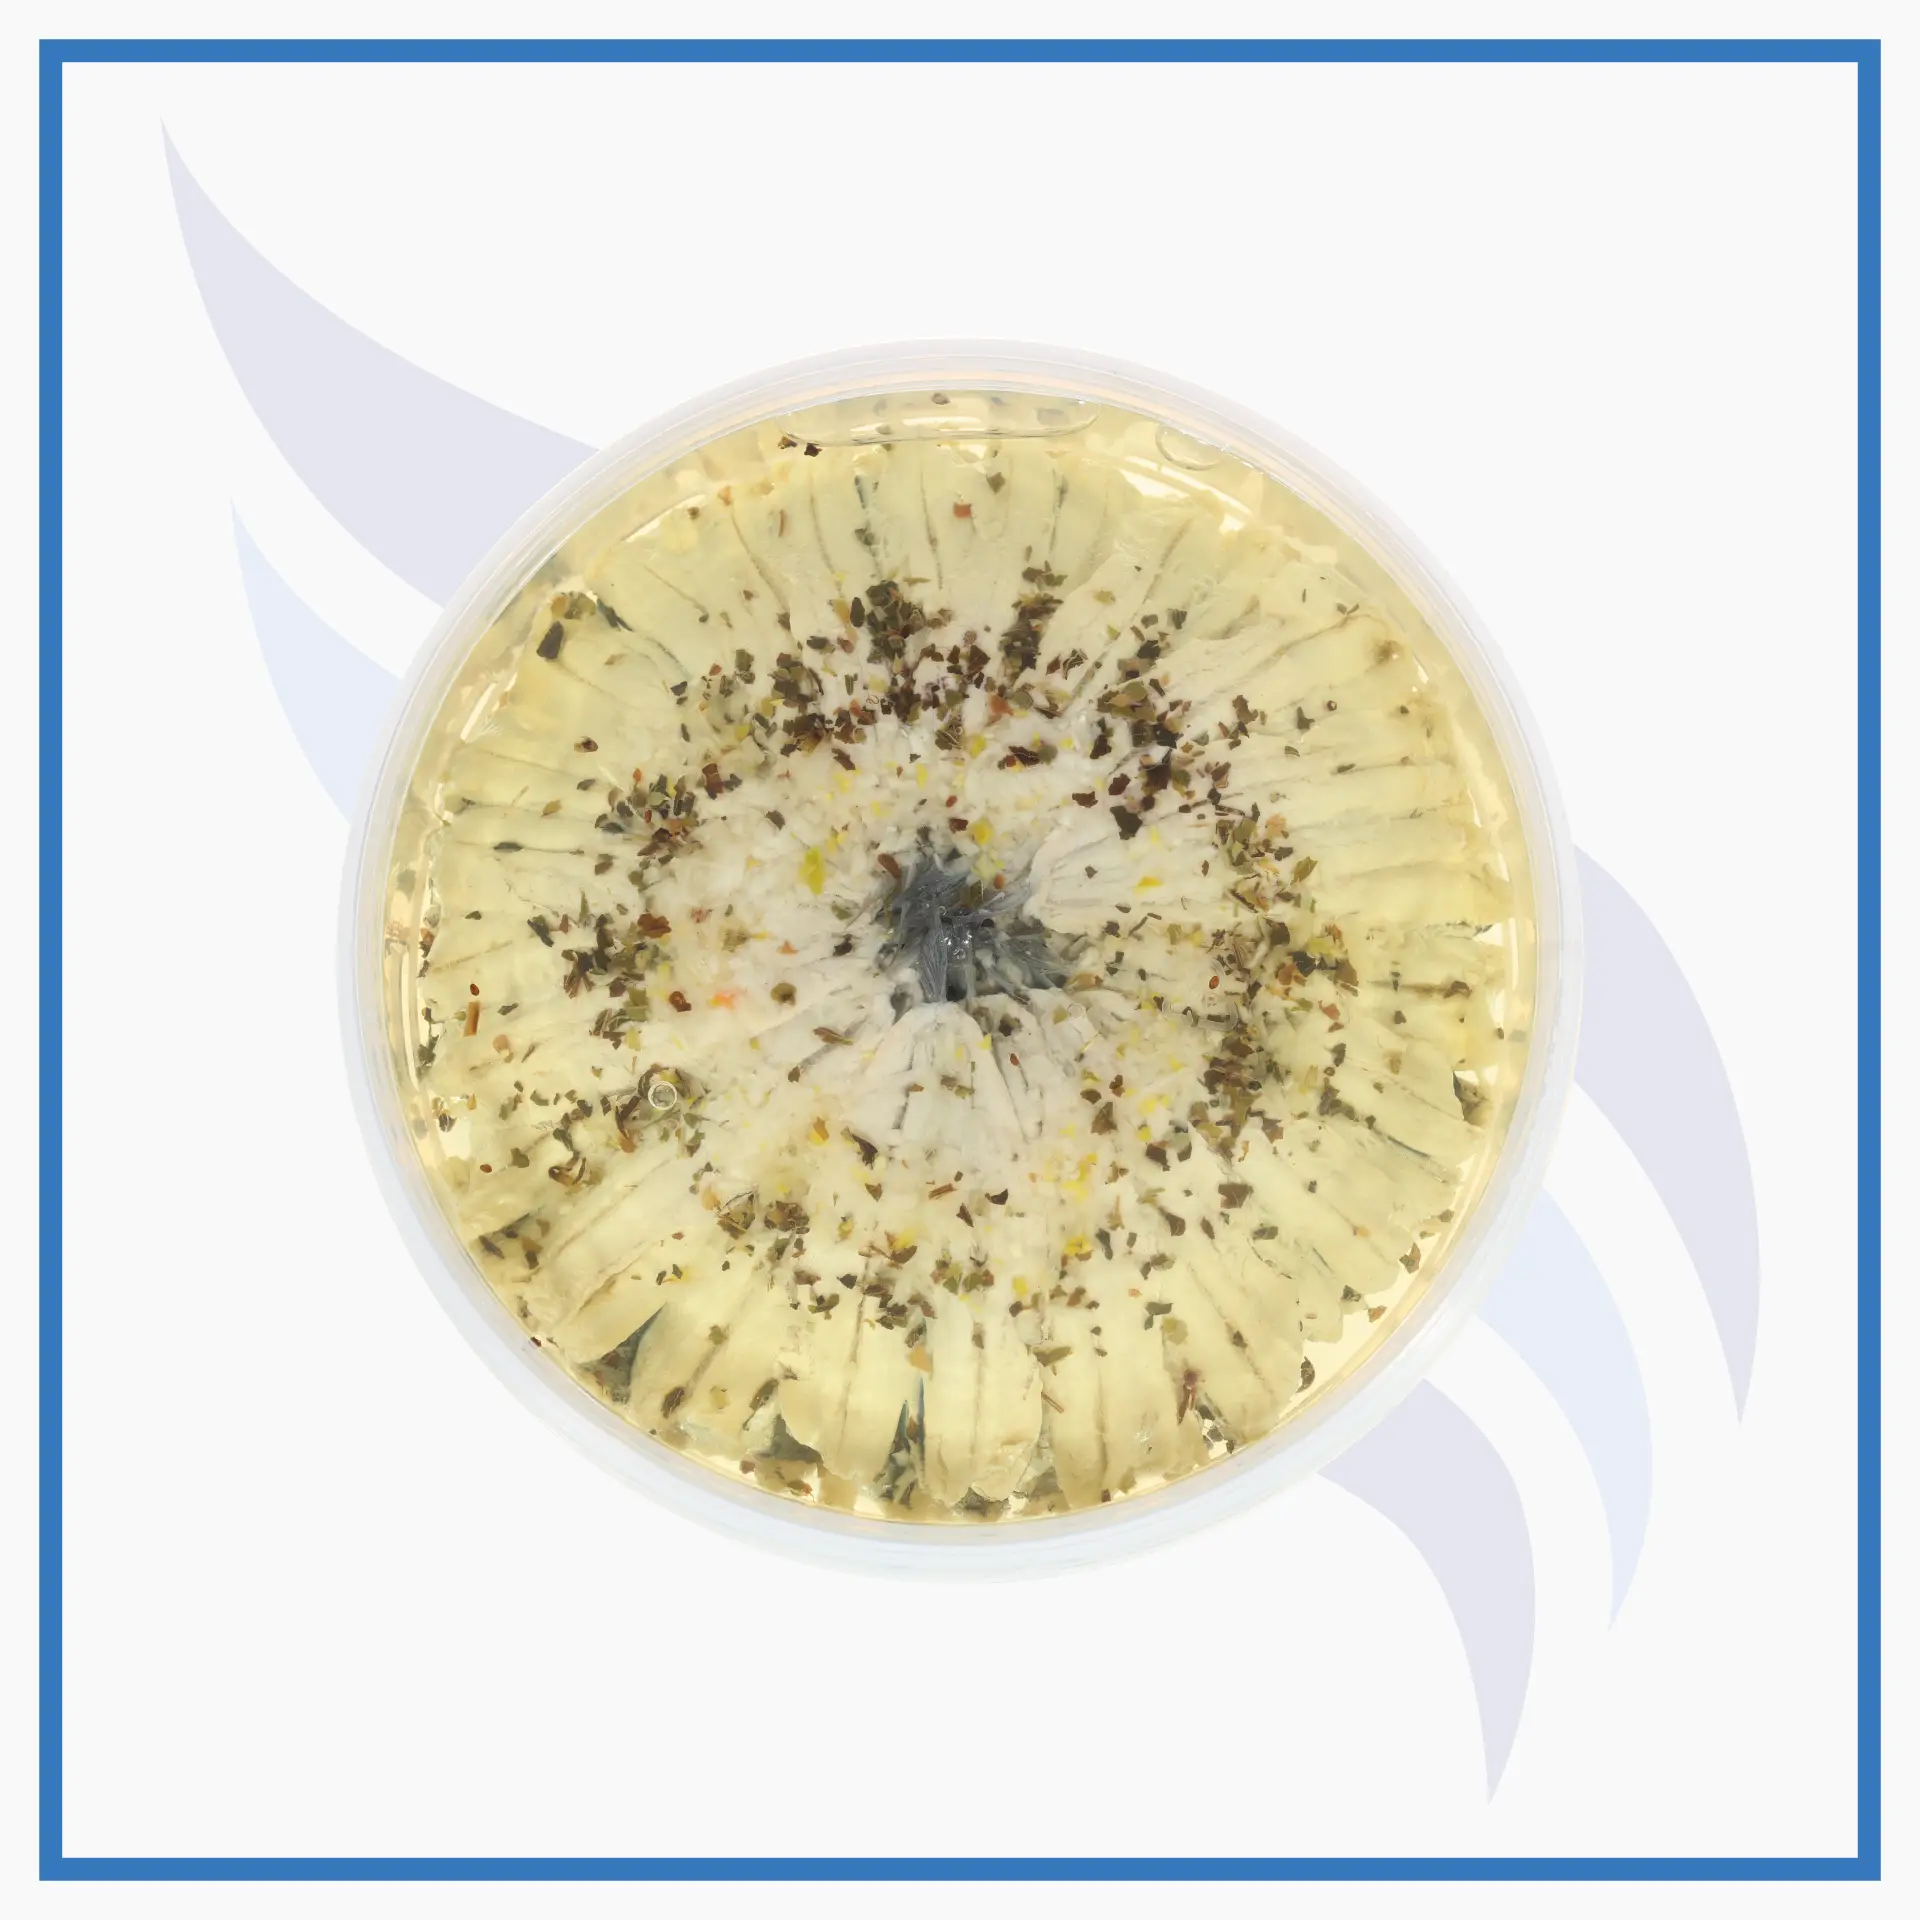
marinat4

DİĞER ÜRÜNLER
Şahin Grup İşleme Tesisinde, birçok su ürünleri türünden 10 dan fazla marinat çeşidi damak lezzetlerine uygun şekilde üretilmekte ve ihraç edilmektedir.
Ayrıca, başta alabalık (somon) havyarı olmak üzere kefal ve sazan gibi balıkların da havyarı ara mamül veya son ürün olarak taze veya donuk olarak işlenmekte ve pazara sunulmaktadır.
KALİTELİ & GÜVENLİ
Üretilen ürünler, tam entegre şekilde ilk tazeliğini koruyarak güvenli şekilde sofralara ulaştırılmaktadır.
SOĞUK ZİNCİRDE HIZLI DAĞITIM
Bütün balıkçılık ve yetiştiricilik ürünleri, ilk noktadan itibaren ulusal ve uluslararası pazarlara en hızlı şekilde dağıtılmaktadır.
7/24 İLETİŞİM
Müşteri sipariş ve önerileri için hafta sonu ve mesai saatleri dışında da iletişim hattı sürekli aktif bulunmaktadır.